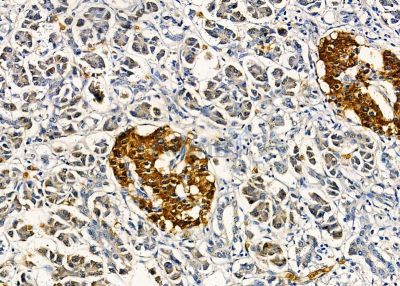
AIFM2 Antibody - DF8636 at 1/100 staining human pancreatic cancer by IHC-P.

AIFM2 Antibody - #DF8636
| Product: | AIFM2 Antibody |
| Catalog: | DF8636 |
| Description: | Rabbit polyclonal antibody to AIFM2 |
| Application: | WB IHC IF/ICC |
| Cited expt.: | WB, IHC, IF/ICC |
| Reactivity: | Human, Mouse, Rat |
| Prediction: | Bovine, Horse, Sheep, Rabbit, Dog, Chicken, Xenopus |
| Mol.Wt.: | 40 kDa; 41kD(Calculated). |
| Uniprot: | Q9BRQ8 |
| RRID: | AB_2841840 |
Product Info
*The optimal dilutions should be determined by the end user. For optimal experimental results, antibody reuse is not recommended.
*Tips:
WB: For western blot detection of denatured protein samples. IHC: For immunohistochemical detection of paraffin sections (IHC-p) or frozen sections (IHC-f) of tissue samples. IF/ICC: For immunofluorescence detection of cell samples. ELISA(peptide): For ELISA detection of antigenic peptide.
Cite Format: Affinity Biosciences Cat# DF8636, RRID:AB_2841840.
Fold/Unfold
5430437E11Rik; aifm2; AIFM2_HUMAN; AMID; Apoptosis inducing factor (AIF) homologous mitochondrion associated inducer of death; Apoptosis inducing factor (AIF) like mitochondrion associated inducer of death; Apoptosis inducing factor mitochondrion associated 2; Apoptosis-inducing factor 2; Apoptosis-inducing factor homologous mitochondrion-associated inducer of death; Apoptosis-inducing factor-like mitochondrion-associated inducer of death; Cys51Stop; HGNC11998; p53 responsive gene 3; p53 tumor suppressor; p53-responsive gene 3 protein; PRG3; TRP53; Tumor protein p53;
Immunogens
A synthesized peptide derived from human AIFM2, corresponding to a region within the internal amino acids.
Detected in most normal tissues as two transcripts of 1.8 and 4.0 kb in length, respectively. Highly expressed in heart, moderately in liver and skeletal muscles, and expressed at low levels in placenta, lung, kidney, and pancreas. Both transcripts expressed following p53/TP53 induction. The shorter 1.8 kb transcript seems to be the major transcript in EB1 colon cancer cells.
- Q9BRQ8 FSP1_HUMAN:
- Protein BLAST With
- NCBI/
- ExPASy/
- Uniprot
MGSQVSVESGALHVVIVGGGFGGIAAASQLQALNVPFMLVDMKDSFHHNVAALRASVETGFAKKTFISYSVTFKDNFRQGLVVGIDLKNQMVLLQGGEALPFSHLILATGSTGPFPGKFNEVSSQQAAIQAYEDMVRQVQRSRFIVVVGGGSAGVEMAAEIKTEYPEKEVTLIHSQVALADKELLPSVRQEVKEILLRKGVQLLLSERVSNLEELPLNEYREYIKVQTDKGTEVATNLVILCTGIKINSSAYRKAFESRLASSGALRVNEHLQVEGHSNVYAIGDCADVRTPKMAYLAGLHANIAVANIVNSVKQRPLQAYKPGALTFLLSMGRNDGVGQISGFYVGRLMVRLTKSRDLFVSTSWKTMRQSPP
Predictions
Score>80(red) has high confidence and is suggested to be used for WB detection. *The prediction model is mainly based on the alignment of immunogen sequences, the results are for reference only, not as the basis of quality assurance.
High(score>80) Medium(80>score>50) Low(score<50) No confidence
Research Backgrounds
A NAD(P)H-dependent oxidoreductase involved in cellular oxidative stress response. At the plasma membrane, catalyzes reduction of coenzyme Q/ubiquinone-10 to ubiquinol-10, a lipophilic radical-trapping antioxidant that prevents lipid oxidative damage and consequently ferroptosis. Cooperates with GPX4 to suppress phospholipid peroxidation and ferroptosis. This anti-ferroptotic function is independent of cellular glutathione levels. May play a role in mitochondrial stress signaling. Upon oxidative stress, associates with the lipid peroxidation end product 4-hydroxy-2-nonenal (HNE) forming a lipid adduct devoid of oxidoreductase activity, which then translocates from mitochondria into the nucleus triggering DNA damage and cell death. Capable of DNA binding in a non-sequence specific way.
N-myristoylation at Gly-2 mediates the recruitment to lipid droplets and plasma membrane.
Lipid droplet. Cell membrane>Lipid-anchor. Cytoplasm. Mitochondrion membrane. Nucleus.
Detected in most normal tissues as two transcripts of 1.8 and 4.0 kb in length, respectively. Highly expressed in heart, moderately in liver and skeletal muscles, and expressed at low levels in placenta, lung, kidney, and pancreas. Both transcripts expressed following p53/TP53 induction. The shorter 1.8 kb transcript seems to be the major transcript in EB1 colon cancer cells.
Belongs to the FAD-dependent oxidoreductase family.
References
Application: WB Species: Mouse Sample: hippocampal tissues
Application: IF/ICC Species: Mouse Sample: hippocampal tissues
Application: WB Species: Mouse Sample:
Application: IHC Species: Human Sample: HCC
Application: WB Species: Human Sample: U87 and LN229 cells
Restrictive clause
Affinity Biosciences tests all products strictly. Citations are provided as a resource for additional applications that have not been validated by Affinity Biosciences. Please choose the appropriate format for each application and consult Materials and Methods sections for additional details about the use of any product in these publications.
For Research Use Only.
Not for use in diagnostic or therapeutic procedures. Not for resale. Not for distribution without written consent. Affinity Biosciences will not be held responsible for patent infringement or other violations that may occur with the use of our products. Affinity Biosciences, Affinity Biosciences Logo and all other trademarks are the property of Affinity Biosciences LTD.